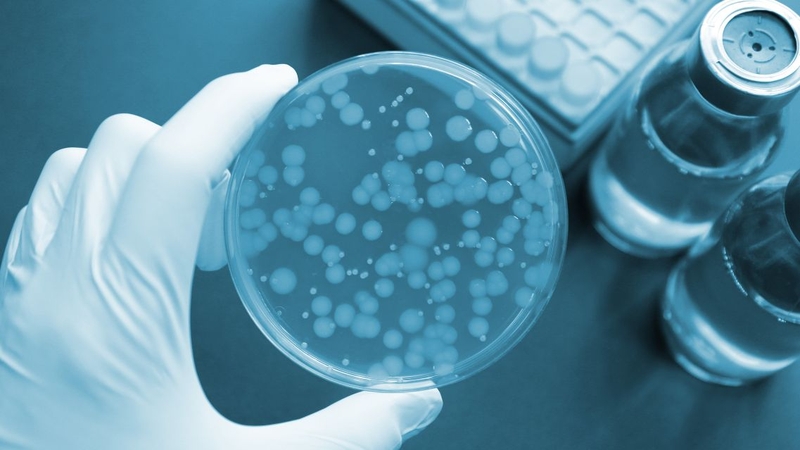
Tìm hiểu chi tiết về phương pháp xét nghiệm cấy dịch não tủy 1

Tốt nghiệp Đại học Y Dược TP. Hồ Chí Minh. Có nhiều năm trong lĩnh vực dược phẩm. Hiện đang là giảng viên cho Dược sĩ tại Nhà thuốc Long Châu.
Thanh Hương
30/10/2025
Mặc định
Lớn hơn
Xét nghiệm cấy dịch não tủy là kỹ thuật quan trọng giúp chẩn đoán chính xác các bệnh lý nguy hiểm như viêm màng não, viêm não, lao màng não,... Bài viết dưới đây của Nhà thuốc Long Châu sẽ giúp bạn hiểu rõ hơn về phương pháp cấy dịch não tủy.
Khi nghi ngờ các bệnh nhiễm trùng nguy hiểm như viêm màng não, viêm não, lao màng não,... cấy dịch não tủy là xét nghiệm chính và có giá trị chẩn đoán hàng đầu. Không chỉ giúp phát hiện chính xác vi khuẩn, nấm gây bệnh, kỹ thuật này còn cung cấp cơ sở quan trọng để bác sĩ lựa chọn phác đồ điều trị phù hợp và kịp thời. Bài viết này sẽ giúp bạn hiểu rõ xét nghiệm cấy dịch não tủy là gì và khi nào cần thực hiện.
Xét nghiệm cấy dịch não tủy là một kỹ thuật vi sinh nhằm phát hiện sự hiện diện của vi sinh vật (vi khuẩn, virus, nấm hoặc kí sinh trùng) trong dịch não tủy (CSF) - chất lỏng bao quanh não và tủy sống. Đây là xét nghiệm quan trọng trong chẩn đoán viêm màng não mô cầu, đặc biệt là viêm màng não do vi khuẩn.
Trong thủ thuật này, bác sĩ sẽ sử dụng một kim chuyên dụng để lấy một lượng nhỏ dịch não tủy từ vùng thắt lưng của người bệnh. Mẫu dịch thu được sẽ được đưa vào môi trường nuôi cấy trong phòng thí nghiệm để tìm vi khuẩn, virus, nấm hoặc kí sinh trùng gây bệnh.
Xét nghiệm cấy dịch não tủy có độ nhạy khoảng 70 - 85% đối với vi khuẩn và đóng vai trò then chốt trong việc chẩn đoán viêm màng não, viêm não, lao màng não và nhiều bệnh lý nhiễm trùng khác liên quan đến não và tủy sống. Nhờ kết quả từ cấy dịch não tủy, bác sĩ có thể xác định được phác đồ điều trị phù hợp, từ đó nâng cao khả năng phục hồi và giảm thiểu biến chứng cho người bệnh.
Xét nghiệm cấy dịch não tủy thường được chỉ định trong những trường hợp nghi ngờ nhiễm trùng thần kinh trung ương, đặc biệt khi bác sĩ muốn xác định chính xác nguyên nhân gây bệnh để có hướng điều trị hiệu quả. Cụ thể, thủ thuật này rất cần thiết khi:
Cấy dịch não tủy là chỉ định bắt buộc khi có nghi ngờ viêm màng não cấp ở trẻ em hoặc người lớn, với các biểu hiện lâm sàng như sốt cao đột ngột, đau đầu dữ dội, cứng gáy, lơ mơ, co giật hoặc hôn mê.
Ở trẻ nhỏ, các dấu hiệu đặc trưng gồm thóp phồng, nôn vọt và ánh mắt nhìn mơ màng. Xét nghiệm này giúp xác định chính xác tác nhân gây bệnh như vi khuẩn, virus hoặc nấm để điều trị kịp thời.
Xét nghiệm cấy dịch não tủy cũng được thực hiện trong quá trình điều trị viêm màng não. Nếu bệnh nhân có triệu chứng không cải thiện hoặc xuất hiện dấu hiệu tái phát, cần làm lại cấy dịch não tủy để đánh giá khả năng tồn tại dai dẳng của vi khuẩn hoặc nhiễm trùng tái phát. Ngoài ra, kết quả cấy còn giúp xác định mức độ nhạy cảm kháng sinh, từ đó điều chỉnh phác đồ điều trị phù hợp.
Khi bệnh nhân có triệu chứng thần kinh tiến triển chậm kéo dài trong nhiều ngày đến vài tuần, cần nghĩ đến các nguyên nhân như lao màng não hoặc nấm màng não.
Trong trường hợp này, dịch não tủy sẽ được lấy để thực hiện các xét nghiệm chuyên biệt như nhuộm Ziehl Neelsen tìm AFB, cấy trên môi trường Lowenstein Jensen đối với lao, hoặc cấy nấm để phát hiện Cryptococcus neoformans.

Bác sĩ cũng sẽ chỉ định xét nghiệm cấy dịch não tủy ở bệnh nhân có tiền sử chấn thương sọ não hoặc can thiệp ngoại thần kinh, nếu xuất hiện sốt kéo dài, thay đổi tri giác, hoặc chảy dịch từ vết mổ. Cấy dịch não tủy trong những trường hợp này giúp phát hiện sớm tình trạng nhiễm trùng để có hướng điều trị kịp thời và phòng ngừa biến chứng nặng.
Thực tế, cấy dịch não tủy là một thủ thuật xâm lấn tối thiểu và hoàn toàn an toàn nếu được thực hiện bởi bác sĩ chuyên khoa được đào tạo bài bản, trong điều kiện vô trùng tại cơ sở y tế. Một số tác dụng phụ người bệnh có thể gặp phải như:

Hiểu rõ quy trình thực hiện sẽ giúp người bệnh và người nhà chuẩn bị tâm lý tốt hơn, tránh lo lắng không cần thiết khi được chỉ định làm xét nghiệm cấy dịch não tủy.
Sau khi được giải thích kỹ thủ thuật và ký cam kết (nếu cần), bệnh nhân được đặt ở tư thế nằm nghiêng co người hoặc ngồi gập lưng để dễ tiếp cận khoang gian đốt sống.
Kỹ thuật chọc dò dịch não tủy phải đảm bảo vô khuẩn tuyệt đối, thường được thực hiện tại khe L3 - L4 hoặc L4 - L5. Sau khi sát khuẩn và gây tê tại chỗ bằng lidocain, bác sĩ sử dụng kim chuyên dụng để đưa vào khoang dưới nhện.
Khi dịch não tủy chảy ra, mẫu được thu vào 3 - 4 ống vô khuẩn theo thứ tự: Ống 1 cho sinh hóa (định lượng protein, glucose), ống 2 cho vi sinh (cấy, nhuộm gram, PCR), ống 3 cho tế bào học và ống 4 (nếu cần) cho các xét nghiệm bổ sung như độc tố hoặc kí sinh trùng.
Ngay sau khi lấy, mẫu dịch não tủy phải được chuyển gấp đến phòng vi sinh để tiến hành cấy trên các môi trường thích hợp. Vi khuẩn được nuôi cấy trên thạch máu hoặc chocolate agar.
Nấm được nuôi cấy trên môi trường Sabouraud, và vi khuẩn lao trên môi trường Lowenstein - Jensen. Mẫu được ủ ở 35 - 37°C và theo dõi sự phát triển vi sinh vật trong ít nhất 48 - 72 giờ. Nếu có mọc khuẩn, phòng xét nghiệm sẽ tiến hành định danh và làm kháng sinh đồ để xác định phác đồ điều trị phù hợp.

Kết quả cấy dịch não tủy thường được trả trong vòng 2 - 3 ngày nếu vi khuẩn phát triển. Tuy nhiên, kết quả có thể âm tính trong trường hợp bệnh nhân đã dùng kháng sinh trước đó, số lượng vi khuẩn thấp hoặc có sai sót kỹ thuật. Do đó, việc chẩn đoán nên phối hợp với các xét nghiệm hỗ trợ khác như nhuộm gram, PCR, phản ứng latex, định lượng glucose, protein và tế bào để đảm bảo độ chính xác.
Xét nghiệm cấy dịch não tủy giúp các bác sĩ có thể xác định chính xác nguyên nhân gây bệnh để can thiệp sớm, giảm thiểu nguy cơ biến chứng nghiêm trọng hoặc tử vong. Nếu thực hiện đúng quy trình, đây là thủ thuật an toàn và hiệu quả. Việc hiểu rõ quy trình, chuẩn bị tâm lý và lựa chọn cơ sở y tế uy tín để thực hiện xét nghiệm này là vô cùng cần thiết.
Dược sĩ Đại họcNguyễn Vũ Kiều Ngân
Tốt nghiệp Đại học Y Dược TP. Hồ Chí Minh. Có nhiều năm trong lĩnh vực dược phẩm. Hiện đang là giảng viên cho Dược sĩ tại Nhà thuốc Long Châu.